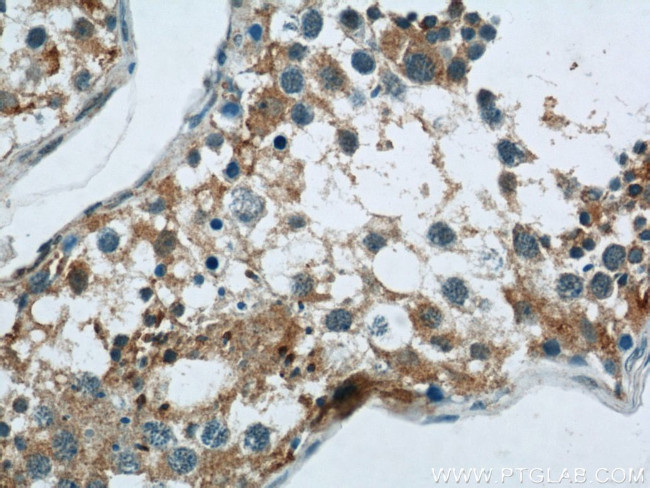
PAOX Antibody in Immunohistochemistry (Paraffin) (IHC (P))

Search
Proteintech
PAOX Polyclonal Antibody
{{$productOrderCtrl.translations['antibody.pdp.commerceCard.promotion.promotions']}}
{{$productOrderCtrl.translations['antibody.pdp.commerceCard.promotion.viewpromo']}}
{{$productOrderCtrl.translations['antibody.pdp.commerceCard.promotion.promocode']}}: {{promo.promoCode}} {{promo.promoTitle}} {{promo.promoDescription}}. {{$productOrderCtrl.translations['antibody.pdp.commerceCard.promotion.learnmore']}}
产品信息
18972-1-AP
种属反应
宿主/亚型
分类
类型
抗原
偶联物
形式
浓度
规格
纯化类型
保存液
内含物
保存条件
运输条件
产品详细信息
Immunogen sequence: RLCGHSAFP HLRVLEATAR AGGRIRSERC FGGVVEVGAH WIHGPSRGNP VFQLAAEYGL LGEKELSQEN QLVETGGHVG LPSVSYASSG ASVSLQLVAE MATLFYGLID QTREFLHAAE TPVPSVGEYL KKEIGQHVAG WTEDEETRKL KLAVLNSFFN LECCVSGTHS MDLVALAPFG EYTVLPGLDC TFSKGYQGLT NCMMAALPED TVVFEKPVKT IHWNGSFQEA AFPGETFPVS VECEDGDRFP AHHVIVTVPL GFLREHLDTF FDPPLPAEKA EAIRKIGFGT NNKIFLEFEE PFWEPDCQLI QLVWEDTSPL EDAAPELQDA WFRKL (31-364 aa encoded by B C032778)
靶标信息
Flavoenzyme which catalyzes the oxidation of N(1)-acetylspermine to spermidine and is thus involved in the polyamine back-conversion (PubMed:12477380). Can also oxidize N(1)-acetylspermidine to putrescine. Substrate specificity: N(1)-acetylspermine = N(1)-acetylspermidine > N(1),N(12)-diacylspermine >> spermine. Does not oxidize spermidine. Plays an important role in the regulation of polyamine intracellular concentration and has the potential to act as a determinant of cellular sensitivity to the antitumor polyamine analogs (PubMed:12477380). [UniProt]
仅用于科研。不用于诊断过程。未经明确授权不得转售。
生物信息学
蛋白别名: exo-N4-amino; PAO-SV10; PAO-SV11; PAO-SV12; PAO-SV13; PAO-SV2; PAO-SV3; PAO-SV4; PAO-SV5; PAO-SV6; PAO-SV7; PAO-SV8; PAO-SV9; Peroxisomal N(1)-acetyl-spermine/spermidine oxidase; peroxisomal N1-acetyl-spermine/spermidine oxidase; Polyamine oxidase; polyamine oxidase (exo-N4-amino); polyamine oxidase; PAO; putative GTP-binding protein; unnamed protein product
基因别名: 2410012F02Rik; AI118225; PAO; PAOX; UNQ1923/PRO4398
UniProt ID: (Human) Q6QHF9, (Mouse) Q8C0L6
Entrez Gene ID: (Human) 196743, (Mouse) 212503, (Rat) 293589